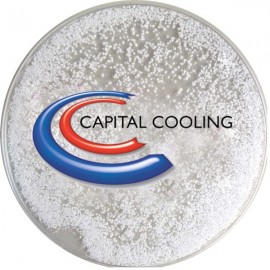
8" Diameter Translucent Mouse Pad - Snow Globe Chips W/ Or W/O Liquid Custom Imprinted

8" Diameter Translucent Mouse Pad - Snow Globe Chips W/ Or W/O Liquid Custom Imprinted - BRAVA Item: QWFZF-FHNFO

$4.47
- 250 or more $8.93
- 500 or more $7.48
- 1000 or more $6.54
- 2500 or more $5.03
- 5000 or more $4.47
Product Code: QWFZF-FHNFO
Setup Cost: $75.00
Color Setup Cost: $75.00
Color Running Charge: 250-$0.20, 500-$0.20, 1,000-$0.20, 2,500-$0.20, 5,000-$0.20.
Freight cost not included.
Description
PromoClear Translucent mouse pad filled with white snow glitter or snow globe chips with or without liquid. Perfect for ski or winter resort destinations, chilly promotions or anything COLD related. Holiday themes as well. Tariff free. 8" DiameterMinimum order size is $300.00. The best way to get more information on any item is to send in a cart. This DOES NOT obligate you to purchase anything. We will contact you shortly after.